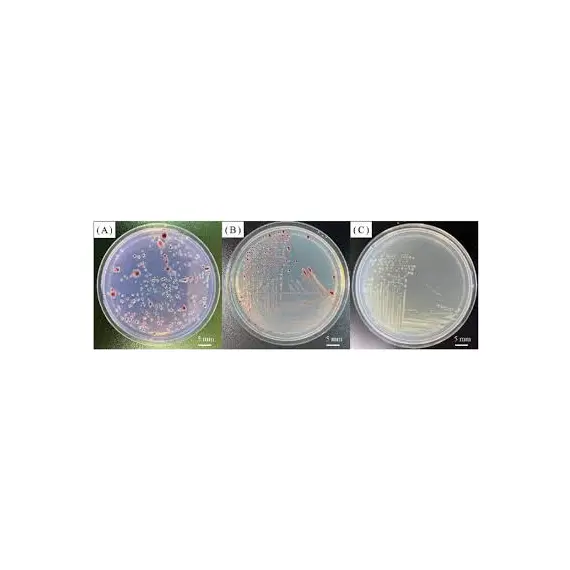

SAMSA (Sequeira Modified Semi-Selective Agar) MEDIUM - Granada & Sequeira, 1983 Pl-25ml
725
Delivery
Payment options
Our advantages
- Fast delivery
- Email notifications
- Different payment methods
- Competitive prices
Find similar
Features
Reviews
No reviews found
Please sign in so that we can notify you about a reply